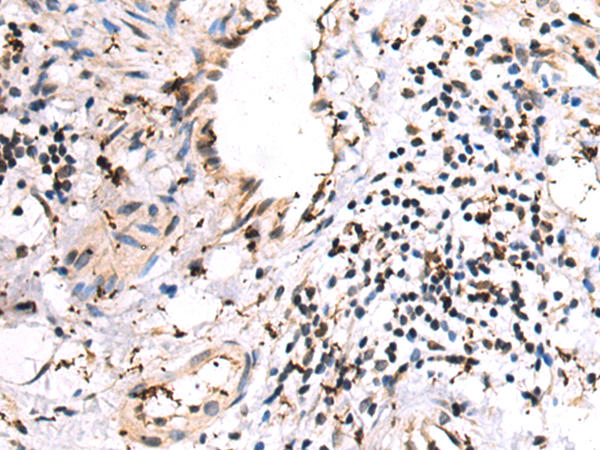
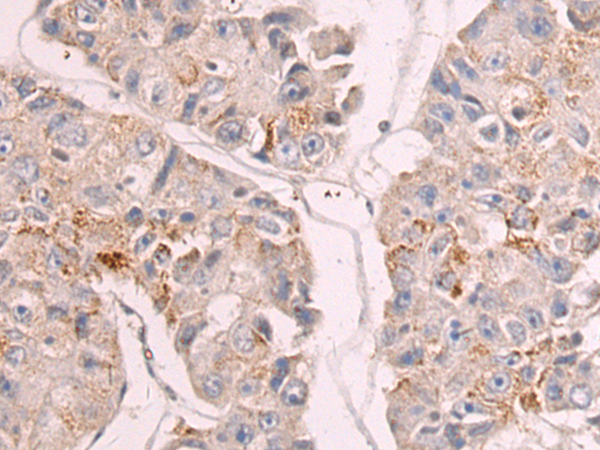

-
分类: 科研抗体货号: P07337别名: CFHL, FHR1, HFL1, HFL2, CFHL1, H36-1, H36-2, CFHL1P, CFHR1P应用: WB,IHC反应种属: Human
-
分类: 科研抗体货号: P07318别名:应用: IHC反应种属: Human, Mouse, Rat
-
分类: 科研抗体货号: P07357别名: MKBP; HSP27; Hs.78846; LOH11CR1K应用: WB,IHC反应种属: Human, Mouse, Rat
-
分类: 科研抗体货号: P07334别名: p55; erg-3应用: WB,IHC反应种属: Human, Mouse
-
分类: 科研抗体货号: P07317别名: ATF1; ATF2; HSCR3; HFB1-GDNF应用: WB反应种属: Human, Mouse, Rat
-
分类: 科研抗体货号: P07355别名: HSP72, HSPA1, HSP70I, HSP70-1, HSP70-1A应用: IHC反应种属: Human, Mouse, Rat
-
分类: 科研抗体货号: P07333别名: MEA5; MGEA5; NCOAT应用: WB,IHC反应种属: Human, Mouse, Rat
-
分类: 科研抗体货号: P07316别名: POF14应用: WB,IHC反应种属: Human, Mouse
-
分类: 科研抗体货号: P07354别名: HSL, LHS应用: IHC反应种属: Human, Mouse, Rat
-
分类: 科研抗体货号: P07332别名: HEL-75应用: WB,IHC反应种属: Human, Mouse, Rat

鄂公网安备42018502007531号
鄂公网安备42018502007531号

